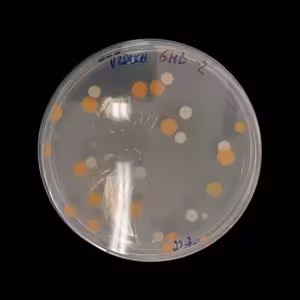
Oči dokorán pre správu a uchovávanie zbierok

Oči dokorán pre správu a uchovávanie zbierok
Správa a uchovávanie zbierkových predmetov je jednou z najdôležitejších úloh múzeí a galérii. Avšak investičný dlh v tejto oblasti je problém, s ktorým zápasia viaceré inštitúcie na Slovensku. Výnimkou nebola ani Galéria mesta Bratislavy, ktorej časť zbierok nebola uložená vo vyhovujúcich podmienkach, a postupom času sa to prejavilo na ich stave. Na prítomnosť plesní v depozitárnych priestoroch a potrebu investícií do lepších podmienok upozorňovalo vedenie galérie roky. Zmena prišla až v roku 2023. Vtedy sa ukončila fáza výstavby nových depozitárov, ktoré vznikli prestavbou bývalých výrobných objektov.
V roku 2022 sa začala spolupráca na záchrane napadnutých predmetov medzi reštaurátorským oddelenim a odborníkmi z Ústavu molekulárnej biológie SAV. Prečo to bolo potrebné a čo je karanténna stratégia o tom rozpráva Barbara Davidson, vedúca reštaurátorského oddelenia GMB a Domenico Pangallo, mikrobiológ z Ústavu molekulárnej biológie SAV.
Podcast Oči dokorán je vložený na túto stránku z otvoreného informačného zdroja RSS. Všetky informácie, texty, predmety ochrany a ďalšie metadáta z informačného zdroja RSS sú majetkom autora podcastu a nie sú vlastníctvom prevádzkovateľa Podmaz, ktorý ani nevytvára ani nezodpovedá za ich obsah podcastov. Ak máš za to, že podcast porušuje práva iných osôb alebo pravidlá Podmaz, môžeš nahlásiť obsah. Ak je toto tvoj podcast a chceš získať kontrolu nad týmto profilom klikni sem.